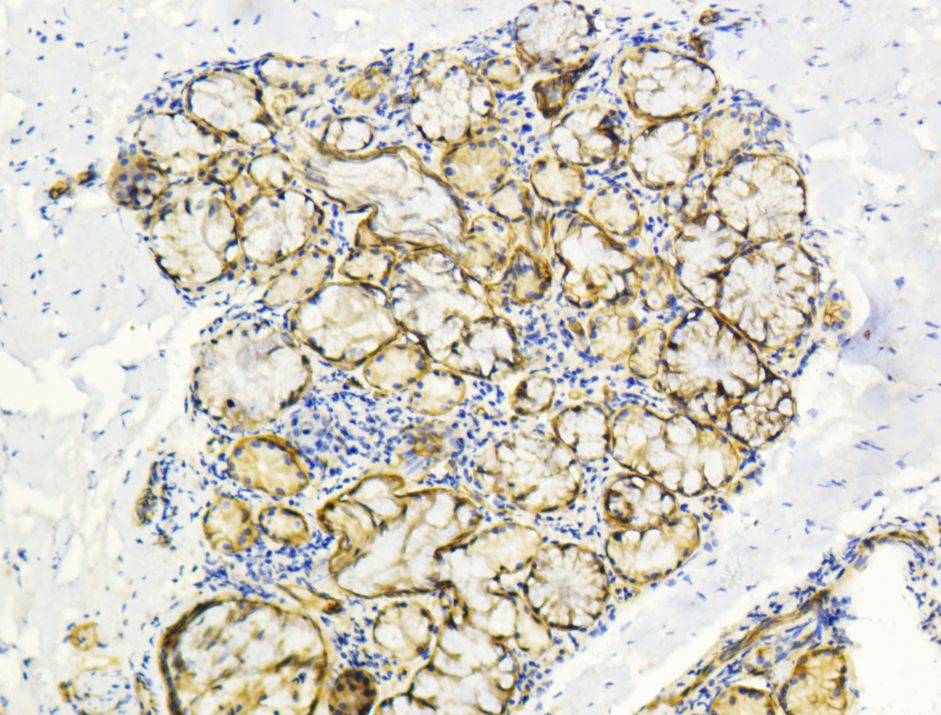

当前位置:首页>蛋白免疫相关试剂>二抗稀释液
产品介绍:
本品适用于免疫组织化学、免疫印迹等实验中二抗的稀释。产品添加了抗体保护剂、稳定剂等成分,有效增加了稀释后抗体的稳定性。使用此二抗稀释液稀释的二抗可以在1-2周内重复使用3-5次。
保存说明:
长期-20℃保存;短期 2-8℃保存。
使用说明:
参考所用的二抗的说明,以及样品中目的蛋白的含量,按照适当比例稀释二抗。二抗稀释后即可直接用于蛋白印迹和免疫染色实验。一次实验结束后,可以回收稀释的二抗,4ºC保存,以用于下次的实验。
注意事项:
1. 本产品宜分装后冻存,切忌多次反复冻融。
2. 本产品仅限于专业人员的科学研究用,不得用于临床诊断或治疗,不得用于食品或药品,不得存放于普通住宅内。
3. 为了您的安全和健康,请穿实验服并戴一次性手套操作。
本产品在文章中的写法:
英文: Dowobio (Shanghai,China)
中文: 上海多沃生物科技有限公司 Dowobio,上海

说明书下载